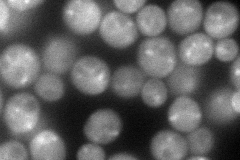
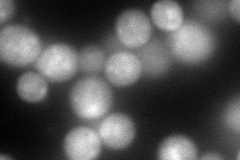
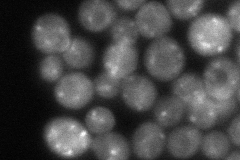
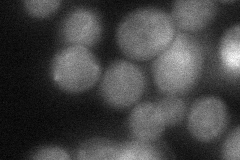

View description
E3 ubiquitin ligase of the NEDD4 family; involved in regulating many cellular processes, including MVB sorting, heat shock response, transcription, and endocytosis; the human homolog is invovled in Liddle syndrome
Localization:
Intensity:
Fold change:
Significance:
-
C’ GFP library in SD

nucleus65.56 -
N' NOP1pr-GFP in SD
cytosol,punctate109.77 -
N' TEF2pr-mCherry in SD
cytosol,punctate173.64 -
N' NATIVEpr-GFP in SD
punctate83.9743 -
N' TEF2pr-VC and Cyto-VN in SD
cytosol,punctate52.4387 -
C’ GFP library in SD+DTT

nucleus57.130.87No -
C’ GFP library in SD+H2O2

nucleus76.261.16No -
C’ GFP library in Starvation Media

nucleus71.251.08No -
C’ GFP library on the background of Pup2-DaMP

nucleus -
C’ GFP library on the background of CCT mutant

nucleus68.63671.04672No
